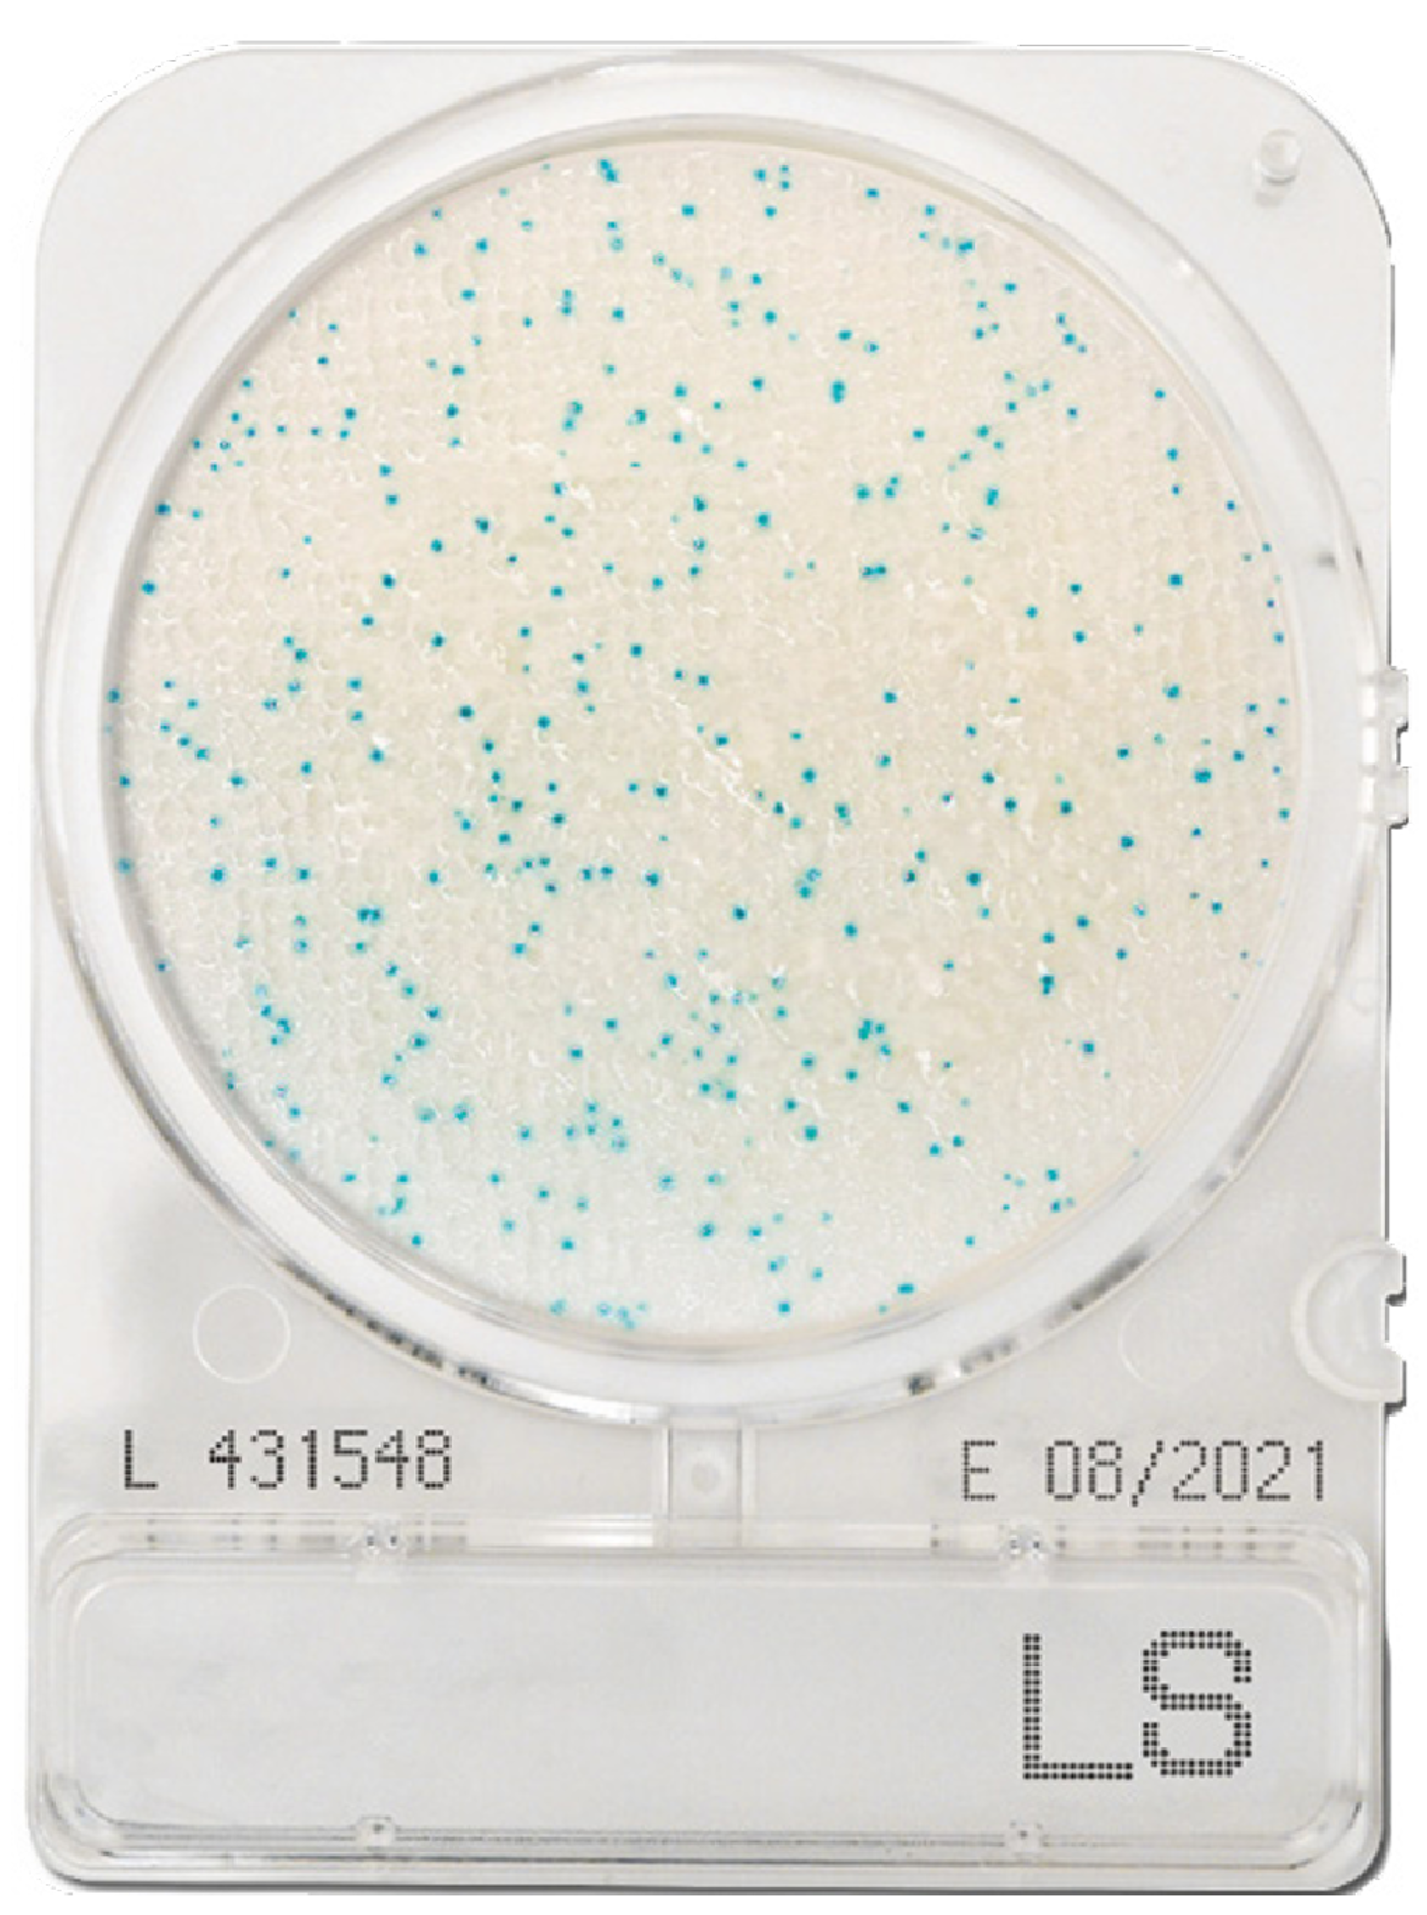
CompactDry LC (Listeria)

Couldn't load pickup availability
CompactDry LC (Listeria): Simple and easy to use diagnostic plate used to detect Listeria contamination in food products or on surfaces. The plates are fully certified and meet the highest accreditation.
The plates contain a specially formulated media which resuspends in seconds, and generates a colorimetric readout upon successful target identification.
Instructions: Simply remove lid, add 1 mL of sample to the membrane, assemble lid, invert and incubate for 2-3 days at 30 degrees. Finally, count the number of colonies and colour to determine the colony forming units (CFU) per mL.
Supplied as a pack of 12 units. Store in a cool dark room. Shelf life up to 24 months.
Pack size: 12, 40, 240 or 1400.
Storage: Cool dark room, shelf life up to 24 months.
Delivery: Less than 2 weeks.